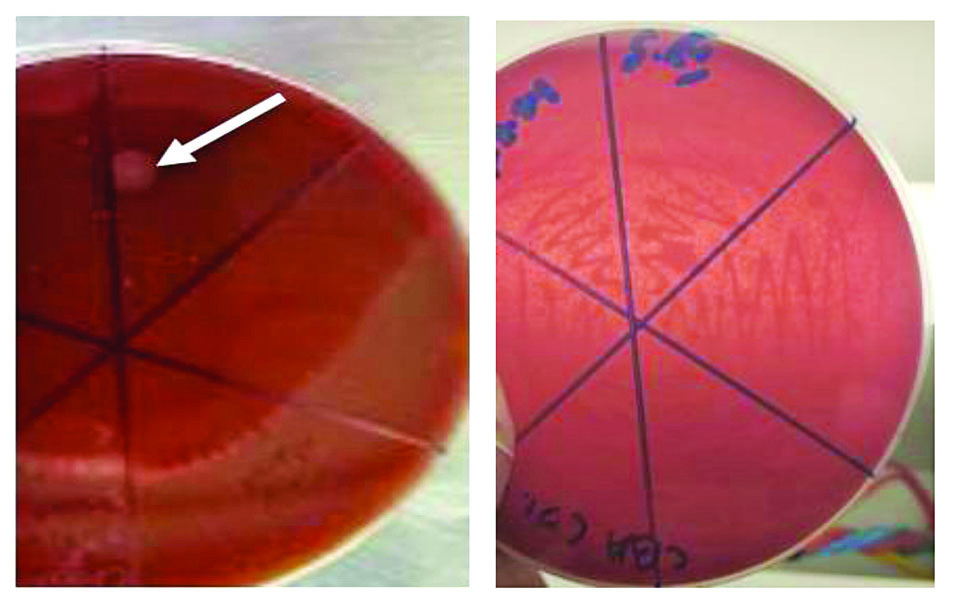
ဆောင်းပါး

ကျွဲ၊ နွား ပေါင်ပုပ် လက်ပုပ်ရောဂါနှင့် ကာကွယ်ဆေးအကြောင်း တစေ့တစောင်း
ဒေါက်တာ ခင်ဥမ္မာလွင်(တိရစ္ဆာန်ဆေးကုဆရာဝန်)
ကျွဲ၊ နွား ပေါင်ပုပ်လက်ပုပ်ရောဂါသည် ပြင်းထန်ပြီး သေဆုံးနှုန်းမြင့်သော ဗက်တီးရီးယားရောဂါ တစ်မျိုးဖြစ်သည်။ ရောဂါဖြစ်ပွားသည့်နေရာရှိ ကြွက်သားသည် မည်း၍ယောင်လာပြီး စမ်းကြည့်ပါက လေခိုသံ (crackling sound) ကို ကြားရသည်။ တိရစ္ဆာန်သည် အစာစားနှုန်းကျခြင်း၊ အနာကြောင့် လဲကျခြင်းနှင့် အပူချိန်မြင့်တက်လာပြီး သေဆုံးကြသည်။ ကူးစက်စေသောရောဂါ မဟုတ်သော်လည်း ကျွဲ၊ နွားငယ်များတွင် ၁၀၀ ရာခိုင်နှုန်းနီးပါး သေဆုံးမှုများသော ရောဂါဖြစ်၍ ကျွဲ၊ နွား မွေးမြူရေးများတွင် အလေးထားဆောင်ရွက်ရန် လိုအပ်ပါသည်။
ရောဂါဖြစ်စေသော အကြောင်းများ
ပေါင်ပုပ် လက်ပုပ်ရောဂါသည် ဗက်တီးရီးယားပိုးအမျိုးအစားဖြစ်သည့် Clostridium chauvoei ကြောင့် ဖြစ်ပွားခြင်းဖြစ်သည်။ သို့သော် Clostridium septicum ပိုးအမျိုးအစားကိုလည်း ရောဂါဖြစ်ပွားသည့်နေရာများမှ တွေ့ရတတ်သည်။ မြန်မာနိုင်ငံ၏ ရာသီဥတု အခြေအနေအရ ကျွဲ၊ နွား ပေါင်ပုပ် လက်ပုပ်ရောဂါသည် ပူပြင်း၍ စိုထိုင်းဆများသောအခြေအနေများ၊ ရုတ်တရက်အေးသောအခြေအနေများတွင် ပို၍အဖြစ်များပြီး အချိန်မရွေးလည်း ဖြစ်ပွားနိုင်သည်။
ကျွဲ၊ နွား၊ သိုးနှင့် ဆိတ်များတွင် အဓိကဖြစ်ပွားသည်။ သမင်၊ ဒရယ်၊ ကုလားအုတ်များတွင်လည်း ရံဖန်ရံခါ ဖြစ်ပွားစေပါသည်။ အသက်ခြောက်လမှ နှစ်နှစ်အတွင်း ကျွဲ၊ နွားများတွင် ပေါင်ပုပ် လက်ပုပ်ရောဂါဖြင့် သေဆုံးမှုနှုန်းများသည်။
ရောဂါကူးစက်ပြန့်ပွားပုံ
စိုစွတ်သော မိုးဦးနှင့် ဆောင်ဦးကာလများတွင် အဖြစ်များသည်။ ရောဂါပိုးသည် မြေကြီးထဲတွင် နှစ်ရှည်ကြာမြင့်စွာ ရှင်သန်နိုင်သည်။ ရောဂါပိုးသည် တိရစ္ဆာန်အစာခြေလမ်းကြောင်း တစ်လျှောက် တိရစ္ဆာန်အား ဒုက္ခမပေးဘဲနေနိုင်သည်။ ရောဂါပိုးသည် မစင်နှင့်အတူ မြေကြီးပေါ်သို့ ကျရောက်ပြီး ရောဂါစတင်ကူးစက်သည်။ ရောဂါပိုးပါရှိသော အစာကို စားသောက်မိရာမှတစ်ဆင့် ရောဂါဖြစ်ပွားစေနိုင်သည်။ အနာဒဏ်ရာမှတစ်ဆင့် ရောဂါပိုးဝင်ရောက်နိုင်သည်။ (ဥပမာ- အမြီးဖြတ်ခြင်း၊ သင်းကွပ်ခြင်း)
ရောဂါလက္ခဏာများ
ရောဂါကျရောက်စတွင် ကျွဲ၊ နွားငယ်အချို့ ရုတ်တရက် သေဆုံးတတ်သည်။ ခြေထောက်နာပြီး လမ်းမလျှောက်နိုင်ခြင်းသည် အဓိကလက္ခဏာတစ်ခုဖြစ်သည်။ ရောဂါဖြစ်စတွင် အပူချိန်မတက်သော်လည်း ခြေထောက်စတင်နာချိန်တွင် အပူချိန်မှာ သာမန် (သို့) သာမန်အောက် ရောက်နေတတ်သည်။ အပူချိန် (၅၅ ဒီဂရီ) အထက်တွင် သေစေနိုင်သည်။
ကြွက်သားပေါများသော ပေါင်၊ တင်ပါး၊ လက်ပြင်၊ ရင်အုပ်၊ လည်ပင်းတို့တွင် ရောင်ရမ်းခြင်းနှင့် ရောင်ရမ်းသည့်နေရာကို လက်ဖြင့်ဖိကြည့်လျှင် ဖောင်းအိ၍ လေခိုနေသည့် အသံကို ကြားရမည်။ ရောဂါလက္ခဏာပြပြီး ၁၂-၂၄ နာရီအတွင်း သေဆုံးနိုင်သည်။
မွေးမြူရေးနှင့် ကုသရေးဦးစီးဌာနမှ ထုတ်လုပ်သော ပေါင်ပုပ် လက်ပုပ်ရောဂါကာကွယ်ဆေး
စိုက်ပျိုးရေး၊ မွေးမြူရေးနှင့် ဆည်မြောင်းဝန်ကြီးဌာန မွေးမြူရေးနှင့် ကုသရေးဦးစီးဌာနသည် အသားကဏ္ဍဖွံ့ဖြိုးတိုးတက်ရန်အတွက် တိရစ္ဆာန်ကူးစက်ရောဂါများ ကြိုတင်ကာကွယ်ပေးခြင်းဖြင့် စားနပ်ရိက္ခာဖူလုံရေးနှင့် ဘေးကင်းလုံခြုံရေးနှင့် ကျေးလက်ဖွံ့ဖြိုးရေးအတွက် အထောက်အကူဖြစ်စေရန် မျှော်မှန်းချက်ဖြင့် တိရစ္ဆာန်ကူးစက်ရောဂါ ကာကွယ်ဆေးထုတ်လုပ်ခြင်းနှင့် တိရစ္ဆာန်ကူးစက်ရောဂါ ကာကွယ်ထိန်းချုပ်ခြင်းကို ရည်ရွယ်ဆောင်ရွက်လျက်ရှိပြီး ပေါင်ပုပ်လက်ပုပ်ရောဂါကာကွယ်ဆေးကို ထုတ်လုပ်လျက်ရှိပါသည်။ လယ်ယာကဏ္ဍတွင် လူတို့နှင့် ဒိုးတူပေါင်ဖက် ဆောင်ရွက်နေသော ကျွဲ၊ နွားများ၏ ရောဂါကာကွယ်စေနိုင်ရန်အတွက် ၁၉၃၈ ခုနှစ်မှ စတင်ထုတ်လုပ်ခဲ့ရာ ၈၆ နှစ် သက်တမ်းရှိခဲ့ပြီ ဖြစ်ပါ သည်။
မွေးမြူရေးနှင့်ကုသရေးဦးစီးဌာနမှ ထုတ်လုပ်သော ပေါင်ပုပ် လက်ပုပ်ရောဂါကာကွယ်ဆေးများ ကို တိုင်းဒေသကြီး/ ပြည်နယ်များ၏ ရောဂါဖြစ်ပွားမှု တွေ့ရှိရမှုအပေါ် မူတည်ထုတ်လုပ်၍ သုံးစွဲမှုကို အောက်ပါအတိုင်း အသေးစိတ်ဖော်ပြထားသော လက်ကမ်းစာစောင်များနှင့် အတူ တိုင်းဒေသကြီး/ ပြည်နယ်များသို့ ဖြန့်ဖြူးပေးလျက်ရှိသည် -
ဆေးဖော်စပ်ပုံ
ပေါင်ပုပ်လက်ပုပ်ရောဂါဖြစ်စေသည့် Clostridium chauvoei ပိုးနှင့် Clostridium septicum မှ ထုတ်သည့် အဆိပ် (Toxin) ကို ပေါင်းစပ်၍ ဖော်မလင် (Formalin) ဖြင့်သတ်ပြီး ကျောက်ချဉ် (Alum) အနည်ချထားသည့် ကာကွယ်ဆေးဖြစ်သည်။ မှိုတားဆေး (Thiomersal) ထည့်သွင်းဖျော်စပ်ထားသည့် ပိုးသေကာကွယ်ဆေး (Alum Precipitated Killed Vaccine) အဖြစ် ဖော်စပ်ထားပြီး ထုတ်လုပ်မှုအဆင့်ဆင့်တွင် ကောင်းမွန်သောထုတ်လုပ်မှုကျင့်စဉ် (Good Manufacturing Practice- GMP) နှင့်အညီ ဖော်စပ်ထုတ်လုပ်ထားပါသည်။
ဆေးအညွှန်း
ကျွဲ၊ နွား၊ သိုး၊ ဆိတ်တို့ကို ပေါင်ပုပ် လက်ပုပ်ရောဂါမှ ကာကွယ်ပေးရန်အတွက် အသုံးပြုသော ဆေးဖြစ်သည်။ ပေါင်ပုပ် လက်ပုပ်ရောဂါ ဖြစ်တတ်သည့်ဒေသများတွင် ကာကွယ်ဆေးကို ခြောက်လတစ်ကြိမ် ထိုးနှံပေးရသည်။
အသုံးပြုပုံ
အသုံးမပြုမီ ပုလင်းကို သေချာစွာလှုပ်ပါ။ ခြောက်လနှင့်အထက် ကျွဲ၊ နွားများကို တစ်ကောင်လျှင် (၂ ဒသမ ၅) စီစီနှုန်းဖြင့် အရေပြားအောက် (သို့မဟုတ်) အသားထဲသို့ ထိုးပေးရသည်။ အသက်ခြောက်လအောက် ကျွဲ၊ နွားငယ်များနှင့် သိုး၊ ဆိတ်တို့ကို (၁ ဒသမ ၂၅) စီစီသာ ထိုးနှံပေးရပါမည်။
ထုပ်ပိုးစနစ်
ကျွဲ၊နွားကောင်ရေ ၄၀ စာအတွက် ၁၀၀ စီစီဝင် ပလတ်စတစ်ပုလင်းဖြင့် ထုတ်လုပ်ပါသည်။
သိမ်းဆည်းခြင်း
အပူချိန် (၂-၈) ဒီဂရီစင်တီဂရိတ် ရေခဲသေတ္တာထဲတွင် သိမ်းဆည်းပါ။
ပေါင်ပုပ် လက်ပုပ်ရောဂါဖြစ်ပွားစေသော Clostridium chauvoei ၏ လက္ခဏာများ
ကာကွယ်ဆေး ထုတ်လုပ်သော ဓာတ်ခွဲခန်းများသည် ပေါင်ပုပ် လက်ပုပ်ရောဂါကို အဓိကဖြစ်ပွားစေသော ဗက်တီးရီးယားပိုး Clostridium chauvoei ကို အသုံးပြု၍ ကာကွယ်ဆေး ထုတ်လုပ်ကြသည်။
Clostridium chauvoei သည် အောက်ဆီဂျင်ကို မနှစ်သက်သော ဗက်တီးရီးယားပိုး (Anaerobic bacteria) ဖြစ်ပြီး အောက်ဆီဂျင်မရှိသောအခြေအနေတွင် ပေါက်ရောက်သည့် ပိုးဖြစ်ပါသည်။ ထို့ကြောင့် Clostridium chauvoei ကို Gram positive ၊ rod-shaped နှင့် anaerobic bacteria ပိုးအမျိုးအစားအဖြစ် သတ်မှတ်ကြသည်။ Soilborne bacteria ဟုလည်း ခေါ်ကြသည်။ ၎င်းပိုးသည် အဆိပ်ငါးမျိုးကို ထုတ်လုပ်နိုင်စွမ်းရှိသည်။ ထိုအဆိပ်ကြောင့်ပင် ရောဂါဖြစ် တိရစ္ဆာန်များသည် ရောဂါပြင်းထန်၍ ၂၄ နာရီအတွင်း သေဆုံးကြရသည်။ သွေးနီဥနှင့် သွေးဖြူဥများကို ဖြိုကွဲစေသော အဆိပ်ငါးမျိုးတို့မှာ အယ်ဖာအဆိပ် (alpha)၊ ဒယ်တာအဆိပ် (delta)၊ ဘီတာအဆိပ် (beta)၊ ဂါမာအဆိပ် (gamma) နှင့် နူရာမီနိဒေ့ (neuraminidase) တို့ ဖြစ်ကြပြီး ပြင်းထန်သောရောဂါကို ဖြစ်စေသည့် အမွေးအမှင်များ (Flagella) ဖြင့်လည်း ဖွဲ့စည်းထားပါသည်။
ရောဂါဖြစ်ပွားသည့် တိရစ္ဆာန် သေဆုံးပြီး နာရီပိုင်းအတွင်း ထိုတိရစ္ဆာန် ၏ နှလုံးသွေး၊ အသည်း၊ သရက်ရွက်တို့မှ နမူနာပစ္စည်း (samples) ကိုယူ၍ သိုးသွေးဖြင့် ပြုလုပ်ထားသော ပိုးပျိုးစာ (Blood agar) ဖြင့် အောက်ဆီဂျင်မရှိသောအခြေအနေ (Anaerobic jar) တွင် ရောဂါပိုးကို ပျိုးယူနိုင်သည်။ Clostridium chauvoei နှင့် Clostridium septicum ပိုးများကို နှိုင်းယှဉ်ဖော်ပြ အပ်ပါသည်။
ပျိုးထားသော Clostridium chauvoei နှင့် Clostridium septicum ဗက်တီးရီးယားပိုးများကို အေးခဲအခြောက်ခံပုံစံ (freeze dried form) ဖြင့် Master seed bacteria များအဖြစ် နှစ်ကြာမြင့်စွာ သိမ်းဆည်းအသုံးပြု နိုင်သည်။
ပေါင်ပုပ်လက်ပုပ်ရောဂါ ကာကွယ်ထိန်းချုပ်ခြင်း
ရောဂါကာကွယ်ခြင်းသည် ကုသခြင်းထက် ထိရောက်ကြောင်းကို သိရှိကြပြီးဖြစ်ပါသည်။ ကျွဲ၊ နွားများ သေဆုံးမှုများမှ ကြိုတင်ကာကွယ်နိုင်ရန် ကာကွယ်ဆေးထိုးနှံခြင်းကို ပုံမှန်ဆောင်ရွက်ရန် လိုအပ်သည်။ ထို့ကြောင့် ကျွဲ၊ နွားများကို အသက်ခြောက်လမှစ၍ ကာကွယ်ဆေးကို ထိုးနှံပေးကြရမည်။ ကာကွယ်ဆေးကို ခြောက်လတစ်ကြိမ် ပုံမှန်ထိုးနှံပေးရပါမည်။ ပေါင်ပုပ် လက်ပုပ်ရောဂါဖြစ်တတ်သည့် ဒေသများ၊ စိုစွတ်သောဆောင်းဦးနှင့် မိုးဦးကာလများတွင် ပုံမှန်ကာကွယ်ဆေးထိုးပေးခြင်းဖြင့် ရောဂါဖြစ်ပွားမှုကို လျှော့ချနိုင်သည်။ ဗက်တီးရီးယားပိုးသည် မြေကြီးတွင် ကြာမြင့်စွာ နေထိုင်နိုင်သဖြင့် ရောဂါဖြစ်ပွားကြောင်း သတင်းရရှိ သည့် စားကျက်များတွင် မိမိတို့၏ ကျွဲ၊ နွားများကို သွားရောက်စားကျက်လွှတ်ကျောင်းခြင်းမှ ရှောင်ကြဉ်ရမည်။ ကာကွယ်ဆေးအသုံးပြုရာတွင် မိမိဒေသနှင့် သင့်လျော်စွာ ပြုပြင်ထုတ်လုပ်ထားသော ကာကွယ်ဆေးသည် အထိရောက်ဆုံးဖြစ်၍ ဦးစားပေးသုံးစွဲခြင်းမှာလည်း ရောဂါကာကွယ်ထိန်းချုပ်ရာတွင် အရေးကြီးပါကြောင်း တစေ့တစောင်း တင်ပြလိုက်ရပေသည်။
ကိုးကား ။ ဆောင်းပါးတွင် အသုံးပြုထားသော ပုံများသည် အင်တာနက်စာမျက်နှာမှ ကူးယူဖော်ပြထားပါသည်။